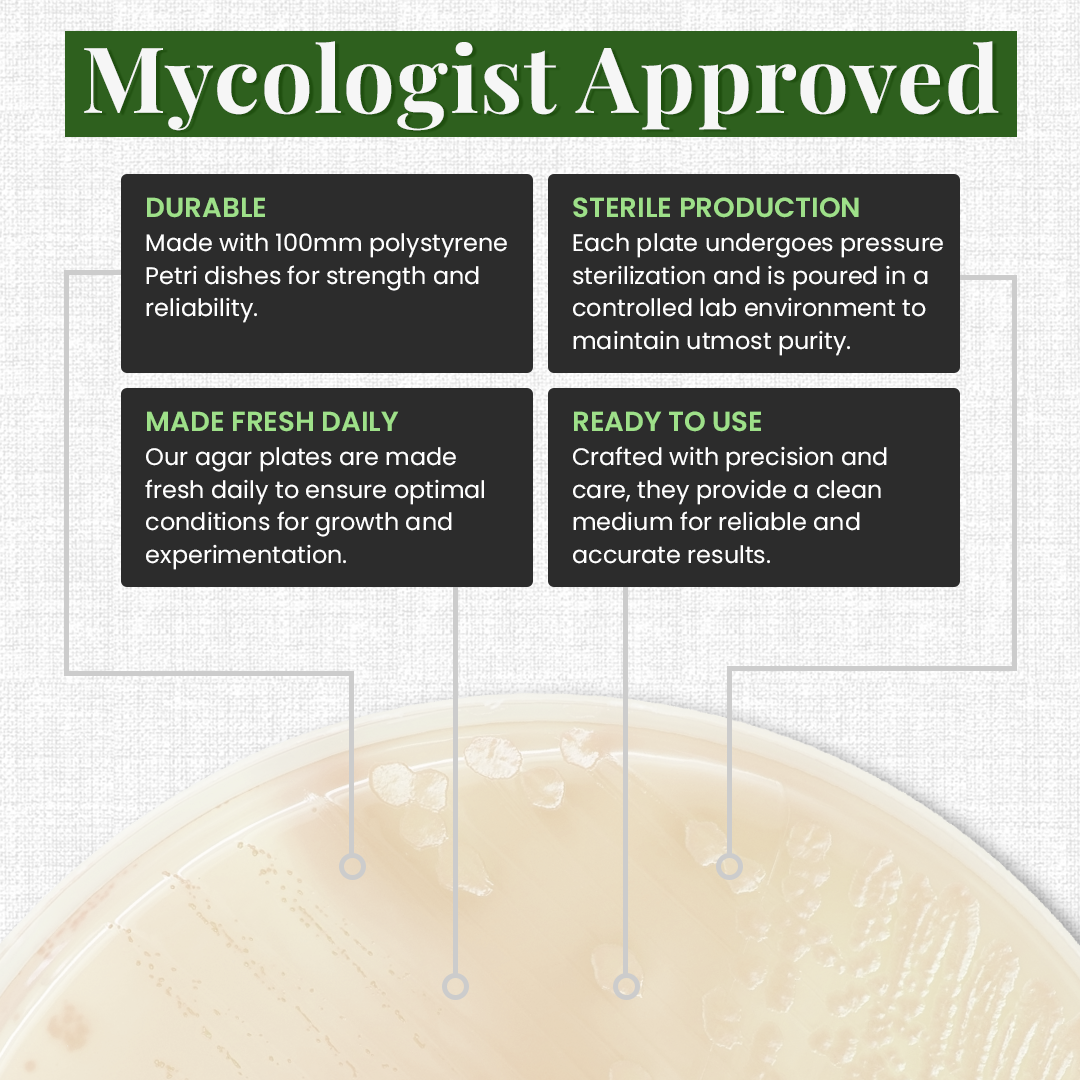

Gro Magik
Gro Magik Pre-Poured Potato, Dextrose and Agar Plates for Mycology, 10-Packs
Gro Magik Pre-Poured Potato, Dextrose and Agar Plates for Mycology, 10-Packs
Couldn't load pickup availability
Achieve Professional-Grade Results with Gro Magik’s Pre-Poured Potato, Dextrose and Yeast Agar Plates
Gro Magik’s pre-poured agar plates are the ultimate solution for anyone looking to cultivate fungi, test molds, or conduct science experiments with ease. Each plate is meticulously prepared with a nutrient-rich light malt extract formula, promoting fast and healthy mycelium growth. Whether you're a beginner exploring the fascinating world of mycology or an experienced cultivator, these sterile plates are designed to deliver consistent, contamination-free results.
- Premium Nutrient Formula – Made with Potato, Dextrose and Yeast extract, these plates provide an optimal environment for robust mycelium growth and organism development.
- Sealed for Freshness – Shrink-wrapped in sets of 5 plates to maintain sterility and freshness, to ensure great results every time.
- Convenient, ready-to-use Potato Dextrose Yeast Agar (PDYA) plates, professionally poured and sealed for optimal sterility.
- Versatile Applications – Ideal for growing mushrooms, cloning specimens, testing, or school science projects which makes it suitable for all levels of expertise.
- Heavy-duty Petri Dishes - Our petri dishes are molded 20% thicker and crack-resistant as well as deeper lids and trays for ease-of use and more efficient cultivating
Frequently Asked Questions
Q: Are these plates ready to use?
A: Yes, they are pre-poured, sterilized, and individually sealed for immediate use.
Q: What types of fungi can I grow on these plates?
A: These plates are ideal for growing a wide range of fungi, including mushrooms like Lion’s Mane and Reishi.
Q: Are the agar dishes sealed?
A: Each agar dish is carefully hand-poured and packaged in sets of five to ensure maximum freshness and minimize the risk of contamination.
Q: Can these plates be used for science projects?
A: Absolutely! They are perfect for educational purposes, mold testing, and more.
Share